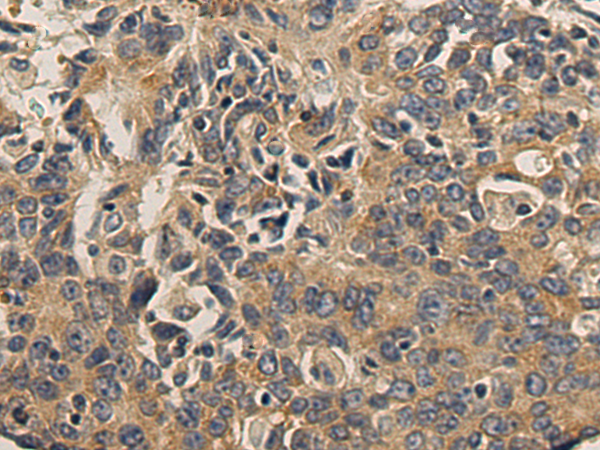

中文名稱:小鼠抗GAPDH單克隆抗體
|
Background: |
This gene encodes tumor protein p53, which responds to diverse cellular stresses to regulate target genes that induce cell cycle arrest, apoptosis, senescence, DNA repair, or changes in metabolism. p53 protein is expressed at low level in normal cells and at a high level in a variety of transformed cell lines, where it's believed to contribute to transformation and malignancy. p53 is a DNA-binding protein containing transcription activation, DNA-binding, and oligomerization domains. It is postulated to bind to a p53-binding site and activate expression of downstream genes that inhibit growth and/or invasion, and thus function as a tumor suppressor. Mutants of p53 that frequently occur in a number of different human cancers fail to bind the consensus DNA binding site, and hence cause the loss of tumor suppressor activity. Alterations of this gene occur not only as somatic mutations in human malignancies, but also as germline mutations in some cancer-prone families with Li-Fraumeni syndrome. Multiple p53 variants due to alternative promoters and multiple alternative splicing have been found. These variants encode distinct isoforms, which can regulate p53 transcriptional activity. |
|
Applications: |
WB, IHC |
|
Name of antibody: |
TP53 |
|
Immunogen: |
Fusion protein of human TP53 |
|
Full name: |
tumor protein p53 |
|
Synonyms: |
P53, BCC7, LFS1, TRP53 |
|
SwissProt: |
P04637 |
|
IHC positive control: |
Human esophagus cancer |
|
IHC Recommend dilution: |
100-500 |
|
WB Predicted band size: |
44 kDa |
|
WB Positive control: |
231, 293T cell lysates |
|
WB Recommended dilution: |
1000-5000 |

購物車
幫助
021-54845833/15800441009
